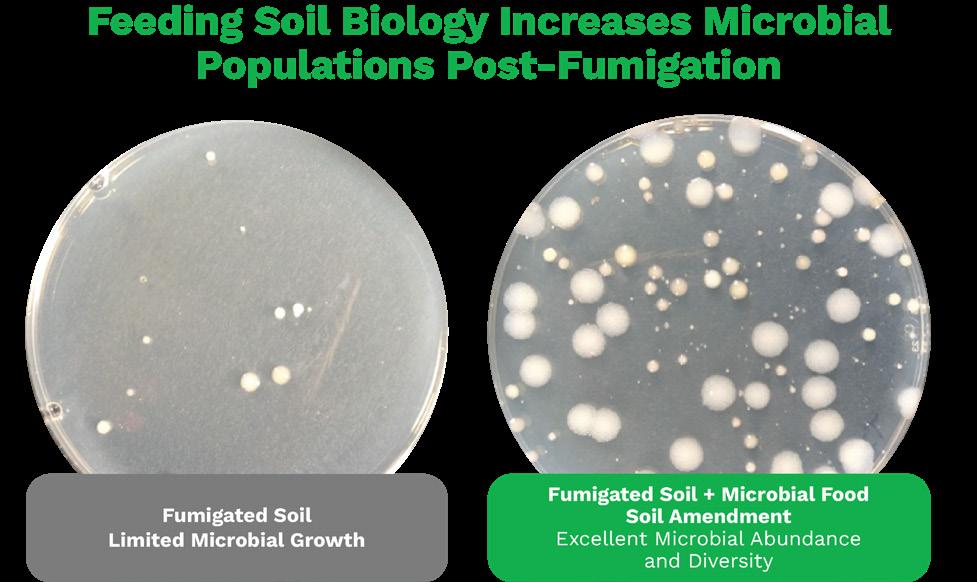

May / June 2024
RNAi Technology: Another Biological Tool in the IPM Arsenal
Tree Temperature Predictions to Improve Chill Accumulation Estimates in Cherry
ACP and HLB: Understanding What California’s Citrus Crop Could Face


Volume 9: Issue 3
JCS MARKETING
POWERED BY
Photo courtesy Citrus Research Board





RNAi AnotherTechnology: Biological Tool in the IPM Arsenal
Making a Case for In-Season Potassium Applications
The TreeChill Model: Tree PredictionsTemperature to Improve Chill Accumulation Estimates in Cherry

PUBLISHER: Jason Scott
Email: jason@jcsmarketinginc.com
EDITOR: Taylor Chalstrom
ASSOCIATE EDITOR: Cecilia Parsons
Email: article@jcsmarketinginc.com
PRODUCTION: design@jcsmarketinginc.com
Satellite-Based Irrigation Tools for More Precise Water Management in Avocado Orchards

Phone: 559.352.4456
Fax: 559.472.3113
Web: www.progressivecrop.com
Mohammad Yaghmour UCCE Farm Advisor, Kern County 10
Crop ConferenceConsultant is the Premiere Event for PCAs, CCAs
Soil Microbiome PostFumigation: Building Soil Microbe Populations Back Stronger
ACP and HLB: Understanding What California’s Citrus Crop Could Face Helping GrowersCalifornia Maximize Profits in 2024
Overcoming Objections in the Field: A Sales Pro's Guide to Engaging California Growers 4 14


CONTRIBUTING WRITERS & INDUSTRY SUPPORT
Allan CCA
Surendra K. Dara Professor and Extension Entomologist, Oregon State University
Paula Guzmán-Delgado Project Scientist, Department of Plant Sciences, UC Davis
Jacquelyn Fernandes Territory Manager, Nutrien Financial
JW Lemons CCA, CPAg
Giulia Marino Associate Professor of Cooperative Extension, Department of Plant Sciences, UC Davis
Million Ph.D., Vice President of Ag Science, Heliae Agriculture
Ali Montazar UCCE Irrigation and Water Management Advisor, San Diego, Riverside and Imperial Counties
Jason Scott MS, Publisher/ CEO, Progressive Crop Consultant, JCS Marketing Inc.
Surendra K. Dara Professor and Extension Entomologist, Oregon State University
Kevin Day UCCE Pomology Farm Advisor, Tulare and Kings Counties
Elizabeth Fichtner UCCE Farm Advisor, Kings and Tulare Counties
Mohammad Yaghmour UCCE Farm Advisor, Kern County UC COOPERATIVE EXTENSION ADVISORY BOARD
Katherine Jarvis-Shean UCCE Orchard Systems Advisor, Sacramento, Solano and Yolo Counties
Steven Koike Tri-Cal Diagnostics
Jhalendra Rijal UCCE Integrated Pest Management Advisor, Stanislaus County
May / June 2024 www.progressivecrop.com 3
4 14 30
IN THIS ISSUE
articles, research, industry updates, company profiles,
advertisements in this publication are the professional opinions of writers and advertisers. Progressive Crop Consultant does not assume any responsibility for the opinions given in the publication.
The
and
John
Cassidy
30 26 22 18 34 38

RNAi Technology: Another Biological Tool in the IPM Arsenal
By SURENDRA K. DARA | Professor and Extension Entomologist, Oregon State University
As food production faces the persistent threat of endemic and invasive pests, researchers continue to develop new technologies and strategies for protecting crops from these threats. One such new technology is RNA interference (RNAi) with targeted mechanisms toward specific pests. RNAi can be used as a trait in a crop or as a sprayable product against the target pest. Before delving further into this, here are a few basic details of this biological process that will help understand the RNAi mechanism.
Deoxyribonucleic acid (DNA) in the chromosomes of most living organisms contains genetic code for making proteins that are essential for various biological processes. Ribonucleic acid (RNA) carries the genetic code from DNA to the protein-making factories within the cell known as ribosomes. DNA has two strands of nucleotides (sets of deoxyribose sugar with nitrogenous bases connected by a phosphate group) whereas RNA has only one strand. RNA also differs from DNA in having ribose sugar, instead of deoxyribose, and a different kind of nitrogenous base. The purpose of RNA is to transfer the genetic code from DNA as amino acids are made in ribosomes. A chain of amino acids makes a specific protein. Examples of proteins in insects include juvenile hormones

The first RNAi-based product was a sprayable developed for the Colorado potato beetle (adult/eggs and larva pictured). RNAi-based products in general have low human and environmental risks. Studies showed dsRNA degraded within two days in soil and one to three days in aquatic environments (photo by Cecilia Parsons.)
responsible for development and reproductive maturation; ecdysone responsible for molting and metamorphosis; digestive enzymes like amylases, glycosidases, lipases and proteases; and esterases that are important in metabolizing various compounds that regulate behavior, development, insecticidal resistance and other processes.
RNAi involves silencing the expression of a specific gene by double-stranded RNA (dsRNA) pieces (either small interfering RNA or microRNA each containing about 21 to 23 nucleotide pairs) attaching to messenger RNA (mRNA) carrying the code from DNA and thus interfering with the production of a specific protein. RNAi is also known as post-transcriptional gene silencing because the silencing is done after the DNA code is transcribed to mRNA. RNAi is a natural phenomenon that helps organisms to defend against infections or regulate gene expression. For example, when there is a viral infection, cells activate RNAi to destroy virus particles. RNAi-based therapies are currently used in the medical field to treat cancer and neurological issues and to regulate oxalic acid in urine or the low-density lipoprotein cholesterol in blood.
Use in Agricultural Crops

RNAi mechanism for gene silencing through a crop trait or a sprayable product (graphic by S. K. Dara, courtesy BioRender.)
RNAi can be used in agriculture for improving yield or quality, imparting abiotic stress tolerance or pest resistance and incorporating other desirable traits or as biopesticides in crop protection (Bharathi et al. 2023; Chaudhary et al. 2024). Many research studies have been exploring the RNAi potential in agriculture for decades (Fletcher et al. 2020). Modifying plant height in apple (Zhao et al. 2016), rice (Qiao et al. 2007) and tomato (Cheng et al. 2020); imparting drought, salt and heat tolerance in cotton (Abdurakhmonov et al. 2014), abiotic stress tolerance in cereal crops (Dubrovna et al. 2023) and cold tolerance in tomato (Jiao et al. 2024); imparting resistance to blast (Magnaporthe grisea) and leaf blight (Xanthomonas oryzae pv. oryzae) in rice (Jiang et al. 2009), citrus canker (Xanthomonas citri subsp citri) in citrus (Enrique et al. 2011), late blight (Phytophthora infestans) in potato (Eschen-Lippold et al. 2012), Fusarium head and seedling blight (Fusarium graminearum) in wheat (Cheng et al. 2015), soybean mosaic virus in
4 Progressive Crop Consultant May / June 2024
PROTECT YOUR BATTLEFIELD HERBICIDES INSECTICIDES
FUNGICIDES
IGRS PGRS

Bootstrapped and ready to serve, Atticus delivers battle-tested chemistries and an experience like no other. Proud to be 100% American-owned and operated, our mission is to help you grow every step of the way.
BATTLE TESTED CHEMISTRIES
ATTICUSLLC.COM ©2024 Atticus. Important: Always read and follow label instructions.
FIND YOUR CROP

RNAi can be used in agriculture for improving yield or quality, imparting abiotic stress tolerance or pest resistance and incorporating other desirable traits or as biopesticides in crop protection (photo courtesy S Dara.)
soybean (Kim et al. 2016); imparting resistance to bollworm (Helicoverpa armigera) in cotton (Mao et al. 2007 and 2011) and resistance to brown planthopper (Nilaparvata lugens) in rice (Zha et al. 2011); and imparting resistance to root-knot nematode (Meloidogyne incognita) in tomato (Dutta et al. 2015) and soybean cyst nematode (Heterodera glycines) in soybean (Guo et al. 2015) are some of the examples of improving crop traits.
The first RNAi crop in the U.S. was corn (SmartStax® PRO) against the western corn rootworm (Diabrotica virgifera virgifera) containing both Bacillus thuringiensis toxins and RNAi technology (Head et al. 2017). With its ability to resist both belowground and aboveground lepidopteran pests, this hybrid is an important IPM tool. This hybrid is also available in Canada for cultivation, and grain and products from the hybrid are approved for consumption in the European Union. RNAi-based crops are not considered genetically modified organisms (GMOs) because they do not contain a foreign gene to express a particular protein like GMOs but use a natural mechanism to silence a particular gene.
In addition to adding desirable traits to crops, RNAi has also been explored or developed for treating plants against pests and diseases. While RNAi crops use the host-induced gene silencing (HIGS) method, RNAi biopesticides use the spray-induced gene silencing (SIGS). SIGS has been explored for controlling Fusarium graminearum in barley (Koch et al. 2016), sucking and/or stem-boring insects in multiple crops (Li et al.
2015; Hunter and Wintermantel, 2021; Jain et al. 2022) and hawthorn spider mite (Amphitetranychus viennensis) in fruit trees and woody ornamentals (Yang et al. 2023). The first sprayable formulation of RNAi-based biopesticide is CalanthaTM from GreenLight Biosciences against the Colorado potato beetle (CPB), Leptinotarsa decemlineata (Rodrigues et al. 2021). The active ingredient is a dsRNA molecule known as Ledprona (Leptinotarsa decemlineata-specific recombinant double-stranded interfering Oligonucleotide GS2). It belongs to a new class of insecticides under group 35 as an RNAi-mediated target suppressor. Applied as a foliar spray, Ledprona suppresses the gene that produces proteasome subunit beta type-5 (PSBT5) in CPB and arrests insect feeding within two to three days after it is ingested, leading to the death of the pest. PSBT5 is an essential protein important in maintaining cellular protein quality by degrading damaged or misfolded proteins or proteins that are no longer needed.
RNAi can also be used to protect honey bees from the Israeli Acute Paralysis Virus (Hunter et al. 2010) and the Varroa mite (Garbian et al. 2012). In field studies, honey bee populations and honey production increased when bees were fed dsRNA for the virus in the presence of virus in the colonies (Hunter et al. 2010). The ectoparasite Varroa mite is a major threat to the honey bee colony health and its management is a significant challenge. When honey bees ingest the mite-specific dsRNA that silences the calcium ion-binding protein known as calmodulin, the dsRNA is transmitted to the Varroa mite feeding on the
hemolymph of the bees, resulting in mite mortality (Garbian et al. 2012).
Minimal Environmental Risk
As with any new technology, it is important to consider the impact of RNAi on the environment and non-target organisms. Environmental risks and regulatory aspects of RNAi-based products have been reviewed in various reports (Liu et al. 2021; De Schutter et al. 2022; Christiaens et al. 2022). Microbial activity, UV radiation and other environmental conditions degrade dsRNA, and they are generally less stable in the environment, especially under the field conditions where they are used (Bachman et al. 2020). Studies showed dsRNA degraded within two days in soil and one to three days in aquatic environments (Dubelman et al. 2014; Fishcer

Oregon State University's Surendra Dara is currently conducting a survey specifically about the use of biologicals for pest management in California. Data from this anonymous survey will be used for a report along with the data from a recent survey on pest management needs in the Pacific Northwest. Fill out the survey at oregonstate.qualtrics.com/ jfe/form/SV_2t6szOEbmryTpNs.
6 Progressive Crop Consultant May / June 2024
et al. 2017). Chen et al. (2023) reported while an RNAi-based biopesticide was highly effective against the 28-spotted ladybeetle (Henosepilachna vigintioctopunctata), a pest of solanaceous crops, it had no non-target effect on the predatory lady beetle Propylea japonica Similarly, studies showed the dsRNA developed for controlling Varroa mite were safe for honey bees (Tan et al. 2016; Vélez et al. 2016) and the monarch butterfly (Danaus plexxippus) whose calmodulin mRNA has a slight match to the Varroa-active dsRNA (Krishnan et al. 2021).
With regards to Ledprona, the U.S. Environmental Protection Agency (EPA) found it has minimal human and environmental risks due to low application rates, rapid microbial degradation in the environment and physiological barriers and degradation mechanisms in mammals. U.S. EPA also gave Ledprona a “No Effect” determination according to the Endangered Species Act.
Environmental instability is one of the
concerns for SIGS, but formulation technology can address this problem. Instead of spraying naked dsRNA, formulating it with layered double hydroxide clay nanoparticles known as BioClay significantly extended the stability of dsRNA. Spraying dsRNA in BioClay provided protection against pepper mild mottle virus and cucumber mosaic virus at least for 20 days, and dsRNA was detected on the leaves 30 days after application (Mitter et al. 2017). Similarly, spraying BioClay-formulated dsRNA 5 days before exposing to virus-containing green peach aphids (Myzus persicae) offered protection against the bean common mosaic virus in cowpea and benth (Nicotiana benthamiana) (Worrall et al. 2019). In a more recent study, BioClay-formulated dsRNA against gray mold (Botrytis cenerea) increased disease protection from one week to three weeks on leaves and five days to 10 days on fruit (Niño-Sánchez et al. 2022).
Arthropod pests and pathogens are resilient and rapidly evolving organisms and can develop resistance to RNAi
technology just like they develop to pesticides or transgenic crops. Whether it is HIGS or SIGS, avoiding heavy reliance on one tool and adopting integrated pest management (IPM) and resistance management strategies is crucial even when using RNAi. An IPM strategy that takes advantage of multiple tools will minimize the risk of resistance development while achieving desired pest suppression.
Resources
Videos about RNAi: https://youtu.be/ xDg6pu7HWz4 and https://youtu.be/ cK-OGB1_ELE
For the full list of references, visit ucanr. edu/blogs/blogcore/postdetail.cfm?postnum=59299. Comments about this article? We want to hear from you. Feel free to email us at article@jcsmarketinginc.com

CINNERGY
IN THE FIELD WITH
Cinnerate® is the right pest management tool to protect from diseases, mites, and insects and produce a high-quality crop. As part of your biocontrol system, it can reduce the cost of mite and insect control year-over-year.
READY FOR A FRUITFUL SEASON? LET’S GO.
FUNGICIDE BACTERICIDE STOPS DISEASE ON CONTACT, DISRUPTS IN-SEASON LIFE STAGES
A FLEXIBLE, SYNERGISTIC TOOL FOR CONTROL AND BALANCE EARLY SEASON MITE AND INSECT MANAGEMENT
May / June 2024 www.progressivecrop.com 7
Multi-Site ®


Transforming Soil Health A Four Year Success Story with Cation EX5 PLUS



 By Dr. Muhammad Ismail Siddiqui | Director R&D and Product Innovations
By Dr. Muhammad Ismail Siddiqui | Director R&D and Product Innovations



Soil sodicity and salinity– a big problem! Here is an efficient and sustainable solution!
Saline sodic soils are an everincreasing problem in agriculture. The presence of high concentrations of Na+, Cl-, Mg2+, and SO42ions in soil solution inhibits growth of many plants (Munns 2002, 2005). This high sodium and salinity levels in agricultural soils pose significant challenges for growers worldwide, negatively impacting crop productivity and soil health High salinity is associated with low soil water potential and specific ions, especially Na+ and Cl-, are potentially toxic at higher concentrations. The toxic effect of Na+ far exceeds that of Cl(Tester & Davenport 2003). High sodium levels can damage soil structure, leading to soil surface crusting. This crust impedes soil water movement and aeration, thereby restricting root growth and limiting overall plant production and efficiency (Priyanka Gangwar et al., 2020).
Pistachio cultivation in central California faces these challenges, impacting crop growth, yield, and soil health. The central San Joaquin Valley, specifically, is an area where evaporation exceeds precipitation (Marino et al., 2019). Traditional gypsum applications have been a go-to solution for mitigating these issues. While gypsum can be an effective amendment for reclaiming salty soils, gypsum's low solubility and slow action can limit its efficiency, especially in modern agricultural settings where quick and effective solutions are often needed.
Additionally, the effectiveness of gypsum application relies on pre-
cipitation events to facilitate its dissolution and movement into the soil profile, which can be unpredictable and dependent on regional climate patterns. Moreover, the logistical requirements associated with broadcast applications of gypsum, such as the need for large quantities of material, machinery for spreading, and labor costs, can further add to the challenges and expenses involved in its use.
In modern agriculture, where efficiency and cost-effectiveness are paramount, alternative soil amendment strategies MUST be considered to address soil sodicity and salinity more effectively. These alternatives could include the use of more solution calcium sources, such as AgroPlantae’s Cation-EX5 PLUS which can provide quicker and more readily available calcium and other important ingredients without the same logistical constraints as gypsum. Unlike traditional gypsum, Cation-EX5 PLUS is injected directly into the drip system, reaching the root zone swiftly and directly. Direct injection enables rapid and efficient infiltration into the soil profile, ensuring the timely and more uniform distribution of calcium ions.
In this article, we explore the results of our research comparing the performance of Cation-EX5 PLUS with traditional gypsum applications in managing sodium and salinity levels in pistachio orchards located in saline and sodic soils in central San Joaquin Valley, California.

Fig.1 Significant reduction of 38% in sodium levels in Cation-EX5 PLUS treated areas compared to the grower standard.

Fig. 2 Significant reduction of 55.2% in SAR levels in the Cation-EX5 PLUS treated areas compared to the grower standard.
8 Progressive Crop Consultant May / June 2024
ADVERTORIAL
In the heart of agricultural innovation, AgroPlantae's groundbreaking solution calcium source, Cation-EX5 PLUS, has sparked a revolution in soil health management. With four years of field trials yielding remarkable results, our commitment to excellence has never been clearer. Over this transformative period, AgroPlantae’s soluble calcium solution has significantly reduced sodium levels by an impressive 38% and SAR by 52% and salinity within the crucial first foot of the soil profile. This groundbreaking achievement not only speaks to the efficacy of our product but also establishes a new era in sustainable soil management practices.
The impact doesn't stop there! In parallel with these remarkable soil improvements, our field trials have also demonstrated substantial enhancements in pistachio yields.
Take, for example, the astounding ~13% increase in dry yield achieved with Cation-EX5 PLUS, equating to a remarkable 129lbs/ac more than the grower standard.
But wait, there’s more! In the final year of our study, the momentum only accelerated, with yields soaring by an astonishing 42%. This remarkable improvement, amounting to an additional

428lbs/ac of yield per acre, underlines the unparalleled potential of AgroPlantae’s Cation-EX5 PLUS
These tangible differences in yield not only translate to increased profitability for growers but also speaks volumes about the transformative power of AgroPlantae’s product and to the enduring impact of our soluble calcium solution on soil health, crop productivity, and grower success.

3 Cation-EX5 PLUS 2021 yielded 13% more dry yield (lbs/ac) compared to the grower standard. Visit AGROPLANTAE.COM or give us a call (559) 498 0388 to learn more!

As we reflect on these four years of innovation and success, one thing becomes abundantly clear: AgroPlantae's Cation-EX5 PLUS isn't just a product; it's a catalyst for change. With its proven ability to enhance soil health, combat salinity, and boost crop yields, our calcium solution is paving the way for a brighter and more sustainable future for agriculture.
May / June 2024 www.progressivecrop.com 9
Fig.
Fig. 4 Cation-EX5 PLUS 2023 yielded 42% more dry yield (lbs/ac) compared to the grower standard.
Making a Case for In-Season Potassium Applications
By JOHN ALLAN | CCA
Nitrogen, phosphorus and potassium (NPK) are three major nutrient components of any fertility program and are developed to maximize crop uptake at a given growth stage. Most nitrogen is applied in-season via fertigation (in California) utilizing common materials such as urea, UAN, CAN17 and CN9. Phosphorus is applied early season or in-season based on crop need and timing. Potassium has become a hot topic over the past 10 years and has evolved from the bulk of K2O being applied preplant or in dormancy to in-season applications to maximize efficiency. In this article, we will discuss the need of applying K in-season via fertigation in annual and perennial crops.
K as an Essential Plant Nutrient
The common practice of applying K preplant for annuals and in the dormant season for permanent crops is an effective method of applying K because it isn’t prone to leaching as negatively charged elements. However, depending on your soil type, K can tie up in heavy clays, especially when soils





are dry. While K doesn’t readily leach through a soil profile it is important to have adequate K soil levels when the crop needs it, preferably in the vicinity of the feeder roots. This is especially important in the summer when evapotranspiration is at its peak. Reminder that K is heavily involved with the opening and closing of the stomata through the guard cells by turgor pressure, which is important for water use efficiency. Plants exposed to growing media with adequate levels of K are more tolerant to drought conditions, suffer less and negative effects on crop yield and quality due to drought conditions are reduced.
Liquid K Options
There are a variety of liquid K sources commonly used in California, all of which have their place in fertility programs. MOP and SOP have been standards for many years. With the introduction of potassium thiosulfate, many advisors have made it their standard due to its high K content (25%) and thiosulfate which adds additional benefits. Potassium hydrox-







10 Progressive Crop Consultant May / June 2024
advanced formulation of DPG Potassium Plus™ allows for higher amounts of potassium to be applied without the risk of phytotoxicity. Easy and Safe For More Information deerpointgroup.com
The
ide has also found a place in California agriculture and has increased in use. Potassium nitrate is fairly new to the California market and has been adopted in many programs due to its ability to blend with other fertilizers like CAN 17 and CN9. High-efficiency K products are widely utilized and, often, are proprietary to retail chains. With all that said, there are many, many options available to inject K in-season.
A key factor in deciding the most suitable K source for your fertilization program is to consider the secondary element that will be supplied with the K (e.g., with MOP, chloride will be added in the system; with SOP and KTS, sulfur will be added; with potassium nitrate, nitrogen will be added in the system; etc.). Therefore, considering the impact of these elements on the balance of the final nutrient solution will also influence crop yield and quality.
Current Practices
Given high fertilizer prices the last few years, we’ve backed off on fall-/winter-applied K applications, especially in almonds where we have successfully mined existing soil K. I am not a grower myself, but I hear from several advisors reducing K in the dormant season hasn’t yet influenced yield or K levels in tissues. This makes a case that perhaps we should be backing off on applying K in the fall/winter to permanent crops. And, perhaps, we should consider doing the same in annual crops, applying less K in preplant and taking a “spoon-feeding” approach, following the nutrient absorption demand of the crop by phenological stage. There is much data suggesting spoon feeding, or continuous fertigation, is beneficial to yield and quality.
The Benefits of Continuous Fertigation
Continuous fertigation is a nutrition management strategy that is built on the principle of small doses of mineral fertilizer with every irrigation event (some may call this ‘spoon-feeding.’) This type of management strategy requires knowledge of input interactions in the plant and soil interface, proper infrastructure for accurate input delivery and decision support tools for proper adaptation. Nitrate-based offerings are considered best suited for these spoon-fed strategies because they move predictably with water through the profile, are plant-available at the time of application and increase uptake of positively charged elements (cations) like calcium and magnesium among others. The agronomic benefits of spoon-feeding N through nitrates are undeniable, and the 4Rs (right source, right place, right rate and right time) should be considered with K as well regarding continuous fertigation.



Direct correlation between K levels and evapotranspiration (ET). While we tend to apply the bulk load of K in the dormant months, it’s important K soil content is maintained May through August, the hottest months of the year.
May / June 2024 www.progressivecrop.com 11
Permanent Crops
In the case of citrus, the peak need for K begins at fruit set and drops off severely postharvest.
Table grapes show a similar trend, although after fruit set, a very high and consistent need for K is required.

Annual Crops
Annual crops are managed slightly differently than perennial crops in that there may or may not be adequate soil K levels at planting based on the previous crop. A soil test is imperative to determine a fertility program for not just K but all essential nutrients. Given annual crops are on a shorter growth cycle, the importance of in-season K applications should be a priority, and, in many cases,
can have a greater impact on yield and quality.
Applying K in-season via fertigation isn’t a new concept; most advisors’ recommendations include liquid K sources in their programs. We’ve seen in recent years reducing the amount of K we apply in the dormant season doesn’t affect yield or quality in most cases. However, following tissue K levels in-season in

Similarly, cantaloupes require more K as the plant begins to produce fruit.
'Given annual crops are on a shorter growth cycle, the importance of in-season K applications should be a priority, and, in many cases, can have a greater impact on yield and quality.'
this case becomes even more important to avoid K deficiency. Rather than banking on existing soil K levels, we should be analyzing tissues consistently and creating prescriptive K recommendations based on the crops’ need. The data indicate that need is in-season. We have many K-based fertilizer options available in California, and we should determine which to use based on crop uptake, temperature, soil moisture and secondary element. And, of course, always consider the 4Rs concept to maximize uptake, efficiency and cost.
Comments about this article? We want to hear from you. Feel free to email us at article@jcsmarketinginc.com
12 Progressive Crop Consultant May / June 2024
Need of K as the tomato plant begins to enter reproductive phase.

Start your soil health journey with us and watch your soil transform. We bring you a full line of eco-friendly soil health solutions to accelerate soil fertility, boost crop yields and quality, and reduce input costs.
Huma.us | 1.800.961.1220
LEARN MORE
AND YOUR SOIL WILL RETURN THE FAVOR.

The TreeChill Model: Tree Temperature Predictions to Improve Chill Accumulation Estimates in Cherry
By GIULIA MARINO | Associate Professor of Cooperative Extension , Department of Plant Sciences, UC Davis, PAULA GUZMÁN-DELGADO | Project Scientist, Department of Plant Sciences, UC Davis, and MOHAMMAD YAGHMOUR | UCCE Farm Advisor, Kern County
Fruit trees need low temperatures during the winter season to break dormancy and ensure synchronized fruit development during the growing season. If winter is warm, bloom will be inadequate, delayed and uneven, cross-pollination will be limited, and fruit set will be reduced, resulting in varying crop sizes and maturity stages at harvest time, which can further reduce yield and substantially impact growers’ returns. To overcome low chill, growers rely on chemical rest breaking agents that ‘mitigate the lack of chill,’ advance and condense bloom and ensure sustainable yields and profitability. However, these products must be applied at the right time to be effective and reduce the risk of phytotoxicity. The time to apply dormancy-breaking agents is currently based on the accumulation of a certain level of chill, given a certain chill model.
Chill Accumulation Models
Different models to calculate winter chill accumulation are available for growers. Some models consider chill hour accumulation as the number of hours below 45 degrees F. The more recent and complex model, referred to as the Dynamic Model, also considers the loss of chill when temperatures are warm for calculating the chill portions. However, all these models have shown differences among locations and years, with this inconsistency being amplified by climate change. These inconsistences have significantly reduced model reliability with profound effects on growers who rely on these calculations for important management practices, such as selecting appropriate cultivars or timing the application of dormancy-breaking products. One weakness of all these models is they base chill accumulation calculation using air temperature as the only environmental factor.
Climatic Shifts and Impact on Chill Accumulation Calculation
Prolonged periods of fog in the Central Valley contributed significantly to chill accumulation in this region. However, the intensity and duration of this fog declined significantly over the years. Analyses of climate from Baldocchi and Waller from UC Berkley published in 2014 showed a reduction of the number of winter fog events in the Central Valley of California by 46% over 33 years. This climate change is reducing chill accumulation and, importantly, is reducing our capability to properly predict chill accumulation with the currently available models based on air temperature only. In fact, on foggy days tree temperatures are very similar to air temperatures (opposite to sunny days when radiation directly heats the tree), leading to tree branches and main scaffolds becoming warmer than air temperature (Figure 1). Thus, air temperatures would
14 Progressive Crop Consultant May / June 2024
Figure 1. Reduction of the frequency of foggy days in the Central Valley. Photographs exemplify a winter foggy day and a sunny day in a cherry orchard when tree temperature is respectively similar and greater than air temperature.

reflect the temperatures trees are experiencing on foggy days but not on clearsky days. Growers have been observing these changes happening for decades now, and researchers have described them in scientific publications, but we still do not have any practical tool to integrate these climatic shifts in our orchards management practices.
Measuring Tree Temperature in California Cherry Orchards
Supported by the California cherry industry, we started in 2020 a series of research trials aiming to characterize cherry tree temperature under different growing conditions. Our final objective was to integrate tree temperature in the chill accumulation models. This would increase their accuracy in predicting chill accumulation, since it is more representative of tree real condition than air temperature, especially in warm and sunny winters.
A large dataset of environmental and physiological parameters was collected for three consecutive seasons in three commercial cherry orchards located in the Lodi (San Joaquin Valley) and

• Reduce sunburn and heat stress
• Increase nut meat weight & lighter meat color
Solar Protectant & Heat Stress Solution
soluble Ortho-silicic acid
specifically designed to alleviate crop abiotic & heat stress and sunburn. It helps to reinforce plant cell walls, creating stronger plants with greater tolerance toward abiotic stress, reduced sunburn potential, and improved light absorption which leads to greater crop quality and marketable yield. This year start early with a planned approach.
• No visual residue
www.sym-agro.com
May / June 2024 www.progressivecrop.com 15
Figure 2. Seasonal trend (hourly values) of air temperature (red) and tree temperature (blue). Tree temperature was measured with a thermocouple installed below the bark in the south exposed side of a main branch in a cherry orchard located in southern California.
Eckosil Shield is a
formulation


Bakersfield (Kern County) areas. We installed meteorological stations in the field to measure weather (mainly air temperature and solar radiation). Tree bark temperature was monitored by inserting thermocouples (very small temperature measuring sensors) just below the bark of branches located at the four cardinal points as demonstrated in Figure 2. As expected, trees were warmer than the air most of the time during clear days. The average difference between tree and air temperatures was about 10 degrees F. The largest temperature difference between trees and air was recorded in the southernmost orchard, where the bark of south-exposed branches was 20 to 25 degrees F warmer than the air.
Tree Chill Accumulation
Using tree temperature instead of air temperature, chill accumulation is lower by about 8 to 12 chill portions. This quantity was not constant between locations, years and branch exposures, as mainly affected by climate conditions. For example, in the San Joaquin Valley, 2021-22, which was a relatively warm winter, the south-exposed branches accumulated 14 chill portions less than the air; in 2022-23, which was a very cold winter, the south-exposed branches accumulated only 5 to 6 chill portions less than the air.
Development of the TreeChill Model
The large dataset collected during the three years of project was used to develop the TreeChill model, a grower-friendly tool that predicts tree temperature based only on environmental parameters easily achievable from public weather stations. The model is highly accurate right now for predicting the temperature of cherry trees located in growing areas where the experiment was performed. As it can be observed in Figure 3, the chill accumulation predicted using the TreeChill model (blue line) is extremely close to the measured tree temperature (black line) and always lower than the measured air temperature (orange line).
16 Progressive Crop Consultant May / June 2024
San Joaquin County 2022/2023 AVAILABLE NOW New Enhanced Formulation to Maximize N and Ca Efficiency Yara North America, Inc. • 1-800-234-9376 • www.yara.us YaraTera® NITRAKAL™ MAX Scan here to learn more 2-YaraTera-Nitrakal-4.75x7.5-ad-0723-R3.indd 1 7/13/23 4:16 PM
Table 1. Chill Portions accumulated from November to March for two experimental locations and two winter seasons and calculated using the air temperature and the bark temperature measured in branches exposed to South and North.

Future Work
We are now working on publishing the TreeChill calculator as an online tool through our Lab website (Tree System Lab at UC Davis) and the Fruit and Nut Research and Information Center website. The calculator automatical ly uses the data from the CIMIS, so researchers and growers will only need

decisions, including dormancy breaking agent applications, cultivar selection, pest control, etc. In the future, we plan to adapt the model to different crops
Comments about this article? We want to hear from you. Feel free to email us at
Helping Farmers Grow NATURALLY Since 1974




O ce: 559-686-3833 Fax: 5 59-686-1453 2904 E. Oakdale Ave. | Tulare, CA 93274 newerafarmservice .com
Figure 3. Chill portion accumulation since November 1 calculated using the tree temperature predicted by our TreeChill model (blue lines), the tree temperature measured with thermocouples (black line) and the air temperature (orange line) from CIMIS for three seasons in the Kern County orchard.
Satellite-Based Irrigation Tools for More Precise Water Management in Avocado Orchards
By ALI MONTAZAR | UCCE Irrigation and Water Management Advisor,

The water requirement of a crop must be satisfied to achieve optimum potential yield. The crop water requirement is called crop evapotranspiration and is usually represented as ETc. By combining reference evapotranspiration (ETo) and the proper crop coefficient (Kc), crop water needs (ETc) can be determined as ETc = ETo × Kc. ETo is an estimation of evapotranspiration for short grass canopy under a well-managed, non-stressed condition. ETo is the main driver to estimate or forecast crop water needs. There are user-friendly, satellite-based irrigation tools available that may assist avocado growers with scheduling irrigation more effectively. These tools provide ETo forecast for up to six days in the future and/or actual ET
at the scale of individual fields. This article introduces three free satellite-based irrigation tools including FRET, IrriSAT and OpenET. A comparison of estimated daily ET by OpenET tool and actual ET measured using Eddy Covariance equipment is also presented for an avocado orchard in San Diego County.
FRET (Forecast Reference Evapotranspiration)
A new alternative to weather station ET is forecast reference ET or FRET (Figure 1). The National Weather Service offers FRET data on the Graphical Forecasts page of their website. FRET is one option in the digital forecast database
'ETo is the main driver to estimate or forecast crop water needs.'
18 Progressive Crop Consultant May / June 2024
San Diego, Riverside and Imperial Counties
Figure 1. A screenshot of the FRET ETo map for the entire U.S. issued on April 26, 2024.
of heat waves in avocado orchards.

display, and you can zoom in to find ETo data for your field up to six days in the future. In other words, FRET will assist growers to have forecast ETo up to the next six days and more effectively
schedule irrigation. FRET is currently available at https://digital.weather.gov/. This tool is particularly useful to forecast crop water needs and schedule running hours of an irrigation system ahead
IrriSAT Irrigation Decision Support System
IrriSAT is a weather-based irrigation management and benchmarking technology that uses remote sensing to provide site-specific crop water management information across large spatial scales (Figure 2). It uses satellite imagery to estimate crop coefficients (Kc) at a 30-meter resolution. IrriSAT calculates Kc from a linear relationship with satellite derived Normalized Difference Vegetation Index (NDVI). Daily crop water use is determined by simply multiplying Kc and ETo observations from a nearby weather station. A beta version of the app is currently available at https://irrisat-cloud.appspot.com/, developed using Google App Engine.
OpenET
OpenET is a new online platform that uses satellites for mapping evapotranspiration (actual ET) at the scale of individual fields and currently can be used
May / June 2024 www.progressivecrop.com 19
Contact us to see how we can help! (559)584-7695 or visit us as www.superiorsoil.com Serving California since 1983
Figure 2. A screenshot of crop coefficients calculated by the IrriSAT Google App. By combining reference evapotranspiration and the Landsat-derived crop coefficient, crop water use can be determined on a 30m x 30m basis such that ETc = ETo × Kc.
in 17 western states (Figure 3). OpenET is produced at a spatial resolution of
2022). The ET estimated from the OpenET models and the OpenET Ensemble

30m x 30m (0.22 acres). Daily, monthly and cumulative ET data are accessible on the OpenET Data Explorer. OpenET is currently available at https://openetdata.org/.
OpenET includes six models that are developed based on full or simplified implementations of the surface energy balance (SEB) approach or relies on surface reflectance data and crop type information to compute ET as a function of canopy density using a crop coefficient approach for agricultural lands. The model acronyms are eeMETRIC, geeSEBAL, DisALEXI, SSEBop, PT-JPL and SIMS. In addition, OpenET provides the OpenET ensemble values calculated from an ensemble of these six models.
OpenET Tool to Estimate Crop Water Needs of Avocado Orchards
A case study was conducted to estimate daily ET values in an avocado orchard in San Diego County over a nine-month period (April 15, 2022 through Dec. 29,
was evaluated versus the actual ET measured using the residual of energy balance approach with a combination of surface renewal and eddy covariance equipment (Figure 4) .
The actual daily ET (measured) ranged between 0.03- and 0.23-inch d−1 over the study period (Figure 5). The cumulative ET and average daily ET were 33.2 and 0.13-inch, respectively (Table 1). Comparing the cumulative ET and average daily ET values estimated from the OpenET models and measured from the eddy covariance equipment indicated the OpenET Ensemble provided an accurate estimation of ET for this experimental site over the study period (nearly 5% overestimates of the cumulative ET); however, this is not a true finding for some other avocado sites.
The geeSEBAL, SSEBop, PT-JPL and SIMS models showed a greater accuracy than the OpenET Ensemble on ET estimates of some other avocado sites.
While more comprehensive efforts are required to evaluate the accuracy of

20 Progressive Crop Consultant May / June 2024
Figure 3. A screenshot of of cumulative ET (inch) for the entire western states. You may zoom on the OpenET map to find your orchard for a specific time (daily, monthly, yearly) and explore the data.
Figure 4. Ground view of surface renewal and eddy covariance ET station in an avocado site in Escondido.

Table 1. Cumulative ET, maximum daily ET and average daily ET estimated by the seven OpenET models and measured using surface renewal equipment in an avocado orchard in Escondido. The comparison was conducted for the period of April 15, 2022 through Dec. 29, 2022. The ET values are reported in inch.

5. Daily ET (actual ET or ETa) estimated by the OpenET models and measured using eddy covariance equipment in an avocado site in Escondido.


OpenET models under different canopy features, row orientations and environmental conditions for avocados, this case study demonstrated a good agreement between the results of the OpenET Ensemble and field measurements for an avocado site.
As a user-friendly, free, satellite-based irrigation tool, it is recommended growers consider using OpenET to manage irrigation water and fertilizer more efficiently. Further analysis and evaluation to adopt OpenET in avocado orchards under various conditions will be developed and shared soon.

Comments about this article? We want to hear from you. Feel free to email us at article@jcsmarketinginc.com
Our copper sulfate pentahydrate in-solution formula is OMRI-listed with systemic capabilities! It’s environmentally friendly using less than an 1/16 lb to 1/8 lb per acre of metallic copper specifically designed to combat agricultural diseases in Grapes including: Brown Rot, Downy Mildew, Phomopsis and Powdery Mildew! Magna-Bon CS 2005 achieved outstanding results in the 2021 UC - Davis Grape Powdery Mildew Fungicide Efficacy Trials! As shown in Table 1 with an infection
Grape Powdery Mildew Fungicide Efficacy Trials
Dr. Akif Eskalen, UC Davis


May / June 2024 www.progressivecrop.com 21 Control Control CS 2005 CS 2005
71% 46% 95% Control!
www.MagnaBon.com Less Copper, More Power!
rate of 71%, CS 2005 had 83% control of Powdery Mildew! In Table 2 with an infection rate of 46%, CS 2005 had 95% control of Powdery Mildew! Application rates of CS 2005 = 20oz per 100 gallons of water per acre, 14 day intervals.
Figure
Crop Consultant Conference is the Premiere Event for PCAs, CCAs

The 2024 Crop Consultant Conference is set to return this September and promises to be the agricultural event of the year. Taking place in the heart of California's Central Valley in Visalia, the conference is an essential gathering for PCAs and CCAs. Hosted by JCS Marketing’s Progressive Crop Consultant magazine and MyAgLife, and Western Region Certified Crop Advisers, a leader in PCA and CCA education, the event offers a unique blend of continuing education (CE), networking and industry insights you won't find anywhere else.
Renowned for its agricultural productivity, the Central Valley is an ideal setting for this conference, which will immerse attendees in an environment that reflects the latest advancements and enduring traditions of California agriculture.
“This strategic location in Visalia allows participants to connect directly with the innovations and practices that are shaping the future of crop consulting,” said JCS Marketing CEO Jason Scott.
Scott said the event's focus on innova-
tive pest control strategies, sustainable farming practices and cutting-edge technology ensures attendees will leave with practical knowledge that can be immediately applied.
Comprehensive CE Opportunities at an Affordable Price
Scott said he recognizes the vital role of continuing education for ag professionals and strives to offer a range of CE opportunities at the conference each year. MyAgLife ensures attendees can earn their credits through early online courses, live event sessions and
22 Progressive Crop Consultant May / June 2024
All photos by Kristin Platts.
“Whether you are a seasoned professional or new to the field, this conference offers the insights, connections and opportunities you need to thrive,” -Jason Scott
post-conference offerings.
“This flexibility allows professionals to manage their schedules while keeping up to date with essential knowledge and skills,” Scott said.
With a registration fee of just $350, the conference is an exceptional value.
“This cost-effective pricing translates to mere pennies per CE credit, making it an unbeatable investment for PCAs and CCAs,” Scott said, adding the affordable fee ensures every participant can access high-quality education and networking without breaking the bank.
An Event Packed with Opportunities
The Crop Consultant Conference is more than just a series of lectures; it's a full-fledged experience designed to benefit all attendees to connect them with industry leaders, decision-makers and peers through structured networking events and informal gatherings.
“It’s a unique chance to build relationships that can lead to new opportunities and collaborations,” Scott said.

Attendees can expect to sit in on innovative seminars and workshops to learn the latest research, cutting-edge technologies, and best practices that are driving the industry forward. They will also have access to the latest products, services and technologies in the agricultural sector during the conference’s trade show, allowing them to engage with exhibitors who are at the forefront of innovation and see firsthand the tools that can enhance your practice.
Scott said the trade show is also a great opportunity for companies who are looking to increase their visibility and establish industry leadership by taking advantage of exclusive sponsorship opportunities.
“Our sponsorship packages offer prominent exposure to a highly targeted audience of ag professionals,” he said.
High Demand and Limited Availability
With its comprehensive educational program, affordable pricing and unparalleled networking opportunities, the Crop Consultant Conference is expected to sell out quickly. Both registrations and sponsorship opportunities are in high demand, so it's crucial to secure your spot early.
“This is an unparalleled opportunity to join your peers and industry leaders in the Central Valley for an event that
promises to be both educational and transformative,” Scott said.
He said the Crop Consultant Conference represents a pivotal moment for ag professionals. By bringing together PCAs, CCAs, researchers and industry experts, the conference fosters a collaborative environment where attendees can enhance their knowledge, skills and professional networks.
“MyAgLife's commitment to providing flexible and accessible CE opportunities makes this event an invaluable resource for those dedicated to excellence in crop consulting,” Scott said.
Act Now: Secure Your Spot
Given the high level of interest and limited availability, it's imperative to act quickly. Avoid the disappointment of missing out on this invaluable event by registering today. The fear of missing out (FOMO) is real, and this is your chance to be part of a transformative experience that will drive your professional growth and industry knowledge.
Visit progressivecrop.com/conference to register and secure your place at the 2024 Crop Consultant Conference.
Comments about this article? We want to hear from you. Feel free to email us at article@jcsmarketinginc.com
May / June 2024 www.progressivecrop.com 23
Sept. 25: 7AM-5PM
Sept. 26: 7AM-2PM

Visalia Convention Center
303 E Acequia Ave, Visalia, CA 93291
Invest in Your Ag Future and Make Critical Connections:
Live Conference and Trade Show
Over 70 Exhibits
Mixer with 2 drinks included
First class dining
2 Breakfasts and 2 Lunches
We're diligently working to launch our online CEU platform. 2024 CEU includes pre-conference hours, in-person sessions, and post-confer- ence courses to ful ll your CEU requirements for the year. Pending nal approvals.
CCA of the Year Award by WRCCA and More...
Attendance is filling up fast and this is one conference you don’t want to miss!
The Best of the Best, Together in One Room!
Co-Hosted by:
$350 FOR ONLY WITHONLINEEXCLUSIVE CEU



Register to Exhibit at:
HOSTED
BY:
Our team is proud to present yet another year of the industry's most insightful and valuable talks, coupled with an unparalleled amount of continuing education units. Get All Your CEU for the Year at the Crop Consultant Conference!
Advancing Pest Management: Innovative Strategies for Industry Leaders

Discover advanced pest management solutions in agriculture, from Carpophilus beetles to nematode and rodent control, with industry collaborations.
Harnessing Science for Agriculture: Breakthroughs in Disease and Weed Control
Delve into the latest scientific advancements in RNAi technology, biofungicides, and soil health to combat diseases and weeds effectively across diverse crops.
Sustainable Practices in Crop Protection: Updates and Insights
Stay informed with the latest updates on anaerobic soil disinfestation, integrated pest management, and the impact of new regulations on traditional pest control methods.


Your Key to the Conference
The MyAgLife App is now more essential than ever for navigating the conference. This year, we're excited to introduce the new CEU Manager feature, allowing you to effortlessly track all your annual credits directly within the app.
May / June 2024 www.progressivecrop.com 25 APP MYAGLIFE.COM/APP
Soil Microbiome PostFumigation: Building Soil Microbe Populations Back Stronger
By CASSIDY MILLION | Ph.D., Vice President of Ag Science, Heliae Agriculture
Fumigation provides a myriad of economic benefits for growers, including pest control, improved food safety and increased yields. High-value crop producers rely on fumigation to aid in the control of soilborne pests, including nematodes, fungi, bacteria and even weeds.
However, fumigants remain controversial due to potential environmental and off-target issues as well as risks to human and animal health. While both the economic and environmental bene-
fits and risks are important to consider when fumigating, what is happening belowground? How is fumigation impacting our soil microbiome, and what are the risks and benefits to consider when considering soil health?
What Happens to Soil Microbes After Soil Fumigation?
Depending on a fumigant’s active ingredient, bacteria, fungi, nematodes and/or weeds are reduced to control pathogen load to produce a healthy crop in the following planting. Once fumi-

gation occurs, a reduction in the target pest should be observed. However, can fumigation impact off-target organisms, or those microbes that fumigant was not intended for?
Fumigants with broad-spectrum activity can affect both target (pathogenic) and non-target (beneficial) microorganisms. This can have an impact on nutrient cycling and plant nutrient uptake, which can negatively impact soil health. The ability for beneficial, non-target organisms to recover is critical as they play an important role in the promotion of soil health. Recent studies have shown within the first four weeks post-fumigation, there is a decrease in the abundance (number) and diversity (different types) of bacteria in fumigated soils compared to untreated soils.
Research shows these affected microbial populations can recover in a relatively short period of time, less than a year after the application of fumigants. But what if you are regularly fumigating your fields year after year? Results have shown that the microbial communities can shift due to fumigation, meaning you may see changes in the functional diversity of these communities or what functions these microbes provide in the soil. The fumigation treatments that cause these community shifts can also contribute to physical, chemical and biological changes in the soil, ultimately degrading soil health. Long-term studies (15+ years) of repeatedly fumigated fields show non-target organisms such as arbuscular mycorrhizal fungi (AMF,
26 Progressive Crop Consultant May / June 2024
Figure 1. The goal of soil fumigation is increased economic benefits for growers. There are some watchouts that can be combated through soil amendments and practices.

which play a role in nutrient and water uptake), gram – and + bacteria, actinomycetes and fungi biomass declined compared to non-fumigated soils.
The impact on the microbial community and recovery is also dependent on the type of fumigant used, with methyl bromide having the most detrimental effects and 1,3-dicloropropene having the least. This research suggests there
may be a negative impact on soil health with repeated long-term fumigation practices.
How to Rebuild Soil Microbes Following Fumigation
Avoiding fumigation all together is likely not an option for all growers. To aid in building back your microbial populations post-fumigation, utilization of soil amendments and practices
can be adopted, including management practices that introduces food sources to increase microbial abundance and diversity to improve your soil and soil health (Table 1). There are many options when it comes to building soil biology and soil health. Some of these practices may have better outcomes based on your current operation.
They’re Hungry! Feed Your Soil Biology
It may seem obvious that a good management choice would be to feed the post-fumigated biology in the soil, but this practice is often missed or overlooked.
After fumigation, the soil still contains fungi and bacteria, and we know that within four weeks to one year, post-fumigation populations begin to recover, and they are ready to go to work for you. The problem? They are starving and will go dormant until conditions improve

PREVENTION CURE HAVE BOTH
Transform your approach to disease management with ProBlad® Verde fungicide and give your almonds what they deserve – elevated disease protection and enhanced nut quality – all while maximizing your profit potential.



May / June 2024 www.progressivecrop.com 27
FLEXIBLE APPLICATION LOCALLY SYSTEMIC CURATIVE & PREVENTATIVE UP TO 7–14 DAYS PROTECTION
Table 1. Practices that can help improve soil biology and improve soil structure.

Research shows farm soils are generally low in the food sources that microbes like to eat, and this food scarcity will limit the activity of your soil biology. The answer? Give them a well-balanced meal to keep their populations up. You have many choices, including microalgae and molasses, etc. Figure 2 is an example of utilizing a microalgae food source to feed the microbes after a fumigation event has occurred. Here you can see a significant increase in microbial populations with a 6.4x increase compared to the fumigated soil alone.
Add Soil Biology
A nother option is to add biology to the soil. There are many options when it
comes to choosing the type (genus and species), but the main concept is to provide selected species of bacteria or fungi to the soil that will benefit your crop and put them to work for you. Live inoculants must stay alive to get the benefit you are looking for, which can be challenging when these sensitive microbes are exposed to changes in temperature and humidity from shipping, storage and field application. If you choose this option, plan carefully about how you are getting these products to the field, including best practices for tank mixing. Make sure your product is viable and high quality before adding to your fields.
‘After fumigation, the soil still contains fungi and bacteria, and we know that within four weeks to one year, postfumigation populations begin to recover...'
Mulches and Compost
This practice is like the first management suggestion but provides a “slow release” food source for the microbes. Not all the carbon in plant mulch and compost is available as microbial food. Instead, it must be chemically and physically broken down before the microbes can take advantage of it. Mulches and compost provide a nutrient source to the soil. Watch out for organic matter that isn’t prepared carefully, as it can contain excess salt and weed seeds.
Reduce Tillage and Improve Your Soil Biology
Field management practices like tillage can be hard on your soil biology, particularly the soil fungi.
For example, when a disk moves through the field, it not only slices through the soil (what you want to happen) but it also slices and dices through all the fungi threads (hyphae) you are trying to grow (what you do not want to happen!). This unintentional result can have a severe impact on the biological
28 Progressive Crop Consultant May / June 2024
Figure 2. The soil on the left shows limited microbial growth post-fumigation. The soil on the right shows increased microbial abundance (number) and diversity (different types) when a microbial food source is applied post-fumigation.
’
contribution to soil structure.
Moreover, excessive tillage can compact your soil structure over time, resulting in potential water management issues. Reducing tillage can improve your soil structure on two fronts by preserving the biology and reducing the crushing and compaction of your soil structure. It’s commonly known that implementing reduced tillage may be difficult in certain operations or in more distributive soil cropping systems, so consider combining multiple practices mentioned for a beneficial alternative.
Cover Crops and Soil Biology
The use of cover crops improves soil quality and structure, builds organic matter and recycles nutrients. Cover crops can be grown in between the rows of permanent crops (e.g., trees and vines) or in the ‘off-season’ for annual crops and can be used to help feed soil microbes. Cover crop roots secrete carbon substances, called exudates, which can help boost the soil fungi and bacteria when a crop is not in the ground. Plus, their fine root hairs can tie soil particles together. Keeping soil alive year-round is key to optimizing biological contribution to soil quality.
Fumigation is a tool to help increase economic benefit for the growers including the control of soilborne pests, improve food safety and increase yield. Fumigation can negatively impact the soil microbiome, and long-term use of fumigation can reduce soil health. However, there are many options to offset any damage done to soil health by utilizing soil amendments and practices to counter the risks of declining soil health. When utilizing agricultural practices, it is best to know the long-term and shortterm risks and benefits of a practice and understand how to reduce those risks with management solutions.
References
Castellano-Hinojosa, A., Boyd, N.S., Strauss, S.L. (2022). Impact of fumigants on non-target soil microorganisms: a review. Journal of Hazardous Materials, Volume 427.
Ibekwe A.M., Papiernik S.K., Gan J, Yates S.R., Yang C.H., Crowley D.E. (2001). Impact of fumigants on soil microbial communities. Appl Environ Microbiol.
Li, X., Skillman, V., Dung, J. et al. (2022). Legacy effects of fumigation on soil bacterial and fungal communities and their response to metam sodium application. Environmental Microbiome, 17, 59.
Dangi, S.R., Tirado-Corbalá, R., Gerik, J., Hanson, B.D. (2017). Effect of LongTerm Continuous Fumigation on Soil Microbial Communities. Agronomy, 7, 37.
Comments about this article? We want to hear from you. Feel free to email us at article@jcsmarketinginc.com


Fast and Effective Broad Spectrum Control of Soft-Bodied Insects, Mites and Fungal Diseases
Gargoil® Insect, Mite & Disease
Control targets pests including mites, aphids, thrips, whiteflies, psyllids and other soft-bodied insects. Gargoil® can also help control immature forms of larger insects such as worms and scale.
ADVANTAGES
■ Apply throughout the season, even day of harvest, no PHI
■ No limits on the number of applications per year
■ Easy-to-use plant-based product
Gargoil® for the Control of Navel Orangeworm Adults in Almonds

Gargoil was applied at 3 qts/150 gallons of water per acre. All products were applied at the start of hull split. Grower standard was Bt/Burkholderia.

Call (760) 599-8855 or visit www.san-agrow.com
May / June 2024 www.progressivecrop.com 29
SAW N GTONSTATEDEPARTMENTOFAGRC U ERU ORGAN C PROGRAM REGISTERED INPUT MATERIAL
Grower Standard 28 3 14 13 51 7 0 1 2 2 Pre-treatment 16 13 9 6 60 50 40 30 20 10 0 Days After Treatment Number NOW Adults/Trap
Arvin, CA 2020 Gargoil
ACP and HLB: Not Just Acronyms Understanding What California’s Citrus Crop Could Face
By JW LEMONS | CCA, CPAg

Acronyms mean a lot when it comes to protecting our citrus industry.
Many Californians are affected by the many acronyms being passed around as plans to protect a valuable agriculture crop in our state are formed. CDFA is leading the charge, with the Citrus Pest and Disease Prevention Division developing a statewide Action Plan for Asian citrus psyllid (ACP) and huanglongbing (HLB) disease.
Action taken to control the spread includes an HLB citrus quarantine in place throughout portions of Los Angeles, Orange, Riverside, San Bernardino, San Diego and Ventura counties in response to HLB detections in those areas. These steps are sometimes perceived negatively by growers. They are, however, necessary. It is a way to try to ensure the fruit goes through a collection and observation period to detect the vector. ACP carry the disease, and when they feed on a healthy tree, they spread the infection.
Quarantines can come with a huge price tag. Increased sorting and detection methods in place increases the cost of doing business as normal. Delay from picking to warehouse could have some adverse effects on the quality of the crop as it pertains to storage and packing. Because we isolate the picked fruit on site it delays cooling and other treatments in the packing sheds. This could allow other diseases to gain a foothold and cause additional losses. With a crop

valued at $2.6 billion (in California) for the 2022-23 season, we can easily see its economic importance. During this season, California accounted for 92% of fresh market production in the U.S.
To put losses from HLB into perspective, we can look at the Florida market. HLB was first detected in 2005. One study (Hodges and Spreen 2012) estimates HLB reduced the value of Florida citrus output by $4.51 billion between the
30 Progressive Crop Consultant May / June 2024
Figure 1. Asian citrus psyllid adult. Psyllids vector huanglongbing, and when they feed on a healthy tree, they spread the infection (all photos courtesy Citrus Research Board.)

2006-07 and 2010-11 crop production years. Many factors of abiotic and biotic stresses play a part in citrus losses. HLB economically affects commercial citrus groves in three ways. First, the disease increases the mortality rate of citrus trees. Second, the disease reduces the marketable yield per tree. Third, greening increases production costs. Yield and quality are inhibited in an infected grove to the point of 100% loss at times. Removal of entire blocks reduces growers’ ability to get positive returns.
Other studies conducted have different loss numbers, but we can see this destructive disease can bring with it additional large economic losses. The three losses previously listed are directly related to trees, fruit and production. Much of this has been a permanent loss to production. What we cannot ignore are the other financial impacts of the disease. Costs of fertilizer and insect control must increase to even try and maintain productivity. We strive to control the insect with numerous sprays and even trunk injections. We supplement the trees’ nutrition to offset the reduced nutrient and water flow capability of an infected tree. In addition to controlling the psyllid, growers can mitigate some of the symptoms of the disease via foliar applications of essential micro- and macronutrients, often supplemented with resistance-enhancing products (Shen et al. 2013a; and Spann et al. 2010a). These applications increase costs by $200 to $600 per acre, depending on the nutrient mix applied (Roka and Muraro 2010).
Maintaining the Market
Less trees and fruit drives consumer prices up and could push buyers away from the citrus market. In one estimate, higher prices for the fruit that is left could still result in a loss to producers in the millions of dollars. The reasoning is even higher fruit and juice prices would not make up for the difference. Because
the decrease in sales would far outweigh the increase in price received. Job losses in the fresh sector and the juice sector in Florida were reported in the tens of thousands. Lost income in the job sector and lost sales taxes for the state can add up quickly. An economy that depends greatly on this crop and job sector suf

BACK AND BETTER THAN EVER

May / June 2024 www.progressivecrop.com
APP MYAGLIFE.COM/APP




Reading additional reports, we might assume job loss would be proportional to the drop in production. One report expected HLB in orange groves would result in the loss of approximately 5,000 jobs per year in Florida’s processing sector. Job loss estimates are consistent with the estimates in Hodges and Spreen (2012), who estimate citrus greening has cost Florida an average of 8,257 jobs per year.
The disease is here in California. Because this disease has struck around the world, researchers and concerned citrus industry participants from numerous countries recently attended the seventh International Research Conference on Huanglongbing (IRCHLB) in March in Riverside, Calif. The sixth IRCHLB was held in Riverside in 2019 with more than 400 attendees from around the world. The global citrus industry continues to fight the battle with new treatments, genetic changes to trees, biostimulants and nutrition.
The theme of this year’s conference was, “Transitioning research to field reality,” and featured keynote speakers who provided research and technical updates regarding the global status of HLB as well as technical and poster sessions presented by many of the leading researchers from around the world. The conference allowed these scientists time to foster collaborations to advance their research and discuss notable and emerging ideas.
In California, we need people to understand and not be confused by acronyms. We cannot begrudge the millions
32 Progressive Crop Consultant May / June 2024
LET US BUY YOU A C OFFEE Scan the Code For A $10 Starbucks ® Gift Card* * The first 1000 individuals to join our mailing list by providing their email addresses will receive a $10 Starbucks gift card via email. Limit one gift card per individual. New subscribers only. Always read and follow label instructions. For the full product warranty, terms and conditions, please visit www.warrantydetails.net or contact us at 1-877-696-4204. Valent BioSciences logo is a registered trademark of Valent BioSciences LLC. Starbucks is a registered trademark of Starbucks Corporation; Starbucks Corporation has not participated in or sponsored this promotion.
Figure 2. Asian citrus psyllid nymphs. The spread of huanglongbing by psyllids increases the mortality rate of citrus trees, reduces marketable yield per tree and increases production costs through greening.
'Action taken to control the spread includes an HLB citrus quarantine in place throughout portions of Los Angeles, Orange, Riverside, San Bernardino, San Diego and Ventura counties in response to HLB detections in those areas.'
of research dollars that will go toward finding solutions. Other funds will go toward action plans to control the spread of this devastating disease and potential loss to a very important part of our state.
Resources
Spreen, Thomas & Baldwin, Jean-
Paul & Futch, Stephen. (2014). An Economic Assessment of the Impact of Huanglongbing on Citrus Tree Plantings in Florida. HortScience. 49. 10521055. 10.21273/HORTSCI.49.8.1052.
Ariel Singerman, Michael E Rogers, The Economic Challenges of Dealing with Citrus Greening: The Case of Florida, Journal of Integrated Pest Management,
Volume 11, Issue 1, 2020, 3, https://doi. org/10.1093/jipm/pmz037
Singerman, A., & Useche, P. (2016). Impact of Citrus Greening on Citrus Operations in Florida. EDIS, FE983.
Vaz da Costa, G., Neves, C. S. V. J., Bassanezi, R. B., Leite Junior, R. P., & Telles, T. S. (2021). Economic impact of Huanglongbing on orange production. Revista Brasileira de Fruticultura, 43(3), 4.
Lopez, J. A., & Durborow, S. L. (2015). Huanglongbing and the California Citrus Industry: A Cost Comparison of Do Nothing vs. Do Something Management Practices. Texas Journal of Agriculture and Natural Resources, 27, 51–68.
Comments about this article? We want to hear from you. Feel free to email us at article@jcsmarketinginc.com

May / June 2024 www.progressivecrop.com 33

Helping California Growers Maximize Profits in 2024
By JACQUELYN FERNANDES | Territory Manager, Nutrien Financial
Putting a farming operation along a profitable path may seem like a simple proposition (spend less to produce the crop than the price it can sell for), but when you look closer, the task is much more nuanced. Solving this equation requires a proactive plan and flexibility for growers to respond to many different scenarios.
Many variables can negatively impact the profitability equation: labor costs, water access/availability, changes in pest management strategy, etc. The chances of enhancing profitability increase when growers put themselves in a stable financial position where they can withstand threats and adapt to variable economic and environmental conditions.
To get there, California growers need to consider several factors that will impact farm finances this year.
Where to Look for Cost Savings
The cost of doing business continues to creep up, but there are savings to be had if you look in the right places.
To start, it’s important to review interest expenses and evaluate different lending options that can impact the cost of borrowing. There will always be a cost to borrowing money, but growers might be overpaying if they don’t research options, particularly in the current rate environment where costs can add up.
Over the last few years, growers have seen a much higher percentage of their profits eaten up by interest expenses due to rising interest rates, which climbed higher than many have seen in a generation. As of March, the Federal Reserve is holding rates steady, but they are still at a 20-year high, so interest rates remain critical.
Growers can’t control rates, but they can take advantage of promotional offers alongside traditional fixed rate financing to bring the total effective interest rate down to a level that, when consolidated, lands below Prime.
Take a hypothetical example where a
34 Progressive Crop Consultant May / June 2024
Jaquelyn Fernandes is a territory manager with Nutrien Financial and recommends now as a good time to evaluate a financial plan and make sure growers are taking steps to positively impact profitability (photo courtesy Nutrien Financial.)
grower finances an equal amount for three different input purchases over the same financing period. In addition to their own in-house financing offer, a retailer may have access to a variety of promotional rate offers on some brands. For example, a financing package might look like:
Product A at 9% APR
Product B at 2% APR
Product C at 4% APR
If this grower paid for these products with their operating line of credit, they would be looking at a financing rate ranging between 7% to 11% APR. If this same grower used the blended approach and took advantage of the option to finance the purchase of all three products, they would bring their effective interest rate down to 5% APR, which adds up to meaningful savings on interest expense.



Be Proactive When It Comes to Managing Cash Flow

Beyond interest rates, California growers can also impact profitability by look ing closely at their cash flow needs and evaluating the terms of any financing programs they participate in to ensure that payment due dates line up with crop schedules.



One of the biggest benefits that comes with strategic use of financing is cash preservation. It’s not enough to have the right mix of crop nutrition and protection products; growers must go a step further and think about how and when they’re paying for those products, whether that strategy affords the amount of financial flexibility they need. For example, growers may experience unexpected costs if they need to adjust their pest management strategy mid-season.
Let’s say a crop is infested by navel orangeworm in July, but a grower won’t have cash on-hand until harvest proceeds are recorded in December. In this
May / June 2024 www.progressivecrop.com 35
Zinc-Shotgun® is a fertilizer that focuses on micronutrients to satisfy needs of customers seeking high zinc with manganese, iron and copper. The micronutrients are completely chelated with natural organic acids, amino acids, and carbohydrates that are readily bio-degradable and supply energy to the plant and soil microflora. Many soils are low in zinc and also require other micronutrients for the growth of good crops. We Are Here to Help Call: 209.720.8040 Visit: WRTAG.COM Mn Fe Zn Cu Complete, organically complexed micronutrient package containing essential elements to improve plant health and growth. Organically complexed with plant based amino acids, organic acids, and complexed polysaccharides. The nutrients are readily absorbed by the plant for a faster response. Designed to be applied both by foliar application and fertigation practices and is also e ective when applied directly to the soil.


X-Cyte™ is a cytokinin product formulated to mitigate abiotic stress to maximum yield. Studies developed over the last five years have shown a significant yield increase when using X-Cyte compared to the grower standard practices.


Westley Selma Westley Westley Terra Bella Westley Westley 5,000 4,000 3 000 2,000 1,000 0 269.6
average increase
addition
fl oz X-Cyte
5
beginning at petal fall. It's
A Corteva Agriscience Business
LBS/A
with the
of 16
for
applications
Time to Get X-Cyted!
X-Cyte™
almonds
higher yield. Scan the QR code to learn more L B S N U T / A Marketable Yield per Acre 2018 2019 2019 2020 2022 2 , 4 2 8 0 2 , 6 8 4 2 2 , 3 7 6 2 2 , 5 5 2 2 2 , 0 4 5 3 2 , 2 5 5 7 3 , 8 1 8 7 4 , 2 0 6 5 2 , 5 0 2 8 2 , 8 7 4 5 1 , 3 9 0 7 1 , 5 9 1 5 2021 2021 2 , 8 7 8 7 3 , 1 6 2 8 Grower Standard Practices 16 fl oz X-Cyte + Grower Standard Practices
your
for
























Nature is our consultant.








Leading crop consultants in over eighty-five countries recommend Kelpak Liquid Seaweed Concentrate for improved tolerance to abiotic stress and reduced transplant shock during tree establishment in citrus and other orchard crops. Scientific trials also indicate significant benefits to root development and fruit mass, ultimately providing the grower with increased yields, excellent returns and peace-of-mind.















SCAN F OR MO R E ON CITRUS VISIT OUR W EBSI T E K ELPA K USA.COM OR CALL US ON : 1- 360 518 9141 For use in Organic Agriculture Washington State Dept. of Agricultur or i
Overcoming Objections in the Field: A Sales Pro's Guide to Engaging California Growers
By JASON SCOTT, MS | Publisher/CEO, Progressive Crop Consultant, JCS Marketing, Inc.
In the world of agricultural sales, particularly within the rich and varied landscapes of California, understanding and overcoming objections is paramount. As experienced sales professionals and crop consultants, your role transcends mere transactional exchanges; it's about building trust, understanding needs and offering solutions that genuinely benefit our farming partners. Here, I'll share my insights on navigating these waters effectively.
1. Listen Intently: Before you can overcome an objection, you need to fully understand it. Listen to the grower’s concerns without interrupting. This not only shows respect but also gives you the necessary information to address their specific issues.
2. Empathize and Validate: Growers want to know you understand their situation. Acknowledge their concerns and empathize with their challenges. A simple “I understand why that could be a concern” goes a long way.
3. Educate and Inform: Use your expertise to educate the grower about the benefits and features of the product. Present data, case studies and testimonials that align with their concerns. Remember, knowledge is power, but it must be relevant to their specific circumstances.
4. Tailor Solutions: Customize your solutions to address the grower's unique needs and conditions. Show how your product or recommendation directly resolves their issues or improves their operations.
5. Highlight ROI: Growers are business owners who care about the
bottom line. Discuss the return on investment and how the product can increase efficiency, yield or quality in the long term.
6. Address Risks Directly: Don't shy away from discussing potential risks. Be honest about them and discuss how these risks can be managed or mitigated. This honesty builds trust and credibility.
7. Utilize Third-Party Validation: Bring in success stories, testimonials or endorsements from other growers and industry experts. Peer approval can be a powerful motivator.
8. Create a Sense of Urgency: Without being pushy, explain any time-sensitive benefits of acting now, such as limited availability, current pricing or seasonal advantages.
9. Offer Trial or Pilot Programs: If possible, offer a trial period or a pilot program. This lowers the barrier to entry by reducing perceived risk.
10. Be Patient but Persistent: Change can be daunting. Allow the grower time to think but follow up regularly. Persistence shows commitment and can often be the key to eventual agreement.
In my years of experience, these strategies have been instrumental in navigating objections and building fruitful relationships with California growers and other agricultural businesses. It’s about more than just selling a product; it’s about fostering partnerships and contributing to the success of their agricultural endeavors.

Remember, every objection is an opportunity in disguise, an opportunity to educate, to build rapport and to find mutual ground. With the right approach, patience and understanding, objections can be transformed into gateways for growth and collaboration. As sales professionals and crop consultants, your goal should always be to serve as trusted advisors, guiding farming partners toward decisions that enrich their lands and their livelihoods.
Comments about this article? We want to hear from you. Feel free to email us at article@jcsmarketinginc.com
38 Progressive Crop Consultant May / June 2024





























 By Dr. Muhammad Ismail Siddiqui | Director R&D and Product Innovations
By Dr. Muhammad Ismail Siddiqui | Director R&D and Product Innovations